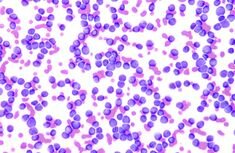
Tuberculosis y Fiebre tifoidea

-
 Los trabajos de un Médico brillante y de reconocido, Johann Peter Frank, quién escribió a inicios del siglo XIX, un tratado de 6 tomos donde exponía el papel que deberían cumplir los estados para contribuir a la salud de sus poblaciones (consideró los aspectos económicos y sociales, como importantes para la salud de la población).
Los trabajos de un Médico brillante y de reconocido, Johann Peter Frank, quién escribió a inicios del siglo XIX, un tratado de 6 tomos donde exponía el papel que deberían cumplir los estados para contribuir a la salud de sus poblaciones (consideró los aspectos económicos y sociales, como importantes para la salud de la población). -
 En Londres, había un desarrollo masivo de fábricas, que producían gran polución ambiental, donde existía una gran explotación de los obreros, a los que les pagaban salarios mínimos y los hacían trabajar un promedio de más de 12 horas diarias. Por estas condiciones laborales los obreros y sus familias vivían en condiciones muy desfavorables, lo que favorecía que fueran víctimas de las enfermedades infecciosas.
En Londres, había un desarrollo masivo de fábricas, que producían gran polución ambiental, donde existía una gran explotación de los obreros, a los que les pagaban salarios mínimos y los hacían trabajar un promedio de más de 12 horas diarias. Por estas condiciones laborales los obreros y sus familias vivían en condiciones muy desfavorables, lo que favorecía que fueran víctimas de las enfermedades infecciosas. -
 En Alemania, el destacado médico RUDOLF VIRCHOW también señalaba que los obreros necesitaban mejores condiciones de vida y que esto era responsabilidad de los gobiernos, por lo que concluyó: “Los Médicos son los abogados naturales de los pobres y los problemas sociales caen en su mayor parte bajo su jurisdicción. La Medicina es una ciencia social y la Política no es otra cosa que la medicinas en gran escala”
En Alemania, el destacado médico RUDOLF VIRCHOW también señalaba que los obreros necesitaban mejores condiciones de vida y que esto era responsabilidad de los gobiernos, por lo que concluyó: “Los Médicos son los abogados naturales de los pobres y los problemas sociales caen en su mayor parte bajo su jurisdicción. La Medicina es una ciencia social y la Política no es otra cosa que la medicinas en gran escala” -
 En Boston, una comisión dirigida por Lemuel Shattuck, llamó la atención sobre las pésimas condiciones sanitarias de la ciudad y recomendaba mejores condiciones de vida, saneamiento ambiental, el control de las enfermedades infecciosas, mejores escuelas de medicina y enfermería, donde se debería hacer énfasis en la enseñanza de la higiene y de la medicina preventiva y la creación de Juntas locales y estatales de Sanidad y de Inspectores de Policía Sanitaria.
En Boston, una comisión dirigida por Lemuel Shattuck, llamó la atención sobre las pésimas condiciones sanitarias de la ciudad y recomendaba mejores condiciones de vida, saneamiento ambiental, el control de las enfermedades infecciosas, mejores escuelas de medicina y enfermería, donde se debería hacer énfasis en la enseñanza de la higiene y de la medicina preventiva y la creación de Juntas locales y estatales de Sanidad y de Inspectores de Policía Sanitaria. -
 Los gobiernos de los países de Europa y América del Norte establecieron por primera vez servicios de salud pública, que en aquella época recibieron la denominación de “SANIDAD E HIGIENE PÚBLICA” cuya finalidad era exclusivamente la protección de la salud de la población, mediante acciones de gobierno dirigidas al medio ambiente y a la colectividad.
Los gobiernos de los países de Europa y América del Norte establecieron por primera vez servicios de salud pública, que en aquella época recibieron la denominación de “SANIDAD E HIGIENE PÚBLICA” cuya finalidad era exclusivamente la protección de la salud de la población, mediante acciones de gobierno dirigidas al medio ambiente y a la colectividad. -
 Winslow en Estados Unidos, redactó la primera definición de Salud Pública: “La salud pública es la ciencia y el arte de impedir las enfermedades, prolongar la vida, fomentar la salud y la eficiencia física y mental, mediante el esfuerzo organizado de la comunidad para: el saneamiento del medio, el control de las enfermedades transmisibles, la educación sanitaria y la organización de los servicios médicos y de enfermería...
Winslow en Estados Unidos, redactó la primera definición de Salud Pública: “La salud pública es la ciencia y el arte de impedir las enfermedades, prolongar la vida, fomentar la salud y la eficiencia física y mental, mediante el esfuerzo organizado de la comunidad para: el saneamiento del medio, el control de las enfermedades transmisibles, la educación sanitaria y la organización de los servicios médicos y de enfermería... -
Como resultado que paulatinamente mejorara la salud de la población, disminuyendo notablemente las enfermedades infecciosas que las agobiaba, tan es así que para 1940 la Tuberculosis y la Fiebre Tifoidea, casos de las fechas señaladas anteriormente, tenían ya baja morbilidad y mortalidad, a pesar de que no se habían descubierto todavía los antibióticos y quimioterápicos.
Como resultado que paulatinamente mejorara la salud de la población, disminuyendo notablemente las enfermedades infecciosas que las agobiaba, tan es así que para 1940 la Tuberculosis y la Fiebre Tifoidea, casos de las fechas señaladas anteriormente, tenían ya baja morbilidad y mortalidad, a pesar de que no se habían descubierto todavía los antibióticos y quimioterápicos. -
 Henry Sigerist en 1948 sostuvo que “la salud se promueve proporcionando condiciones de vida decentes, buenas condiciones de trabajo, educación, cultura física y formas de esparcimiento y descanso” y llamó PROMOCIÓN DE LA SALUD a la tarea de lograr el acceso de la población a ella”
Henry Sigerist en 1948 sostuvo que “la salud se promueve proporcionando condiciones de vida decentes, buenas condiciones de trabajo, educación, cultura física y formas de esparcimiento y descanso” y llamó PROMOCIÓN DE LA SALUD a la tarea de lograr el acceso de la población a ella” -
 Se produjo la Declaración de Alma Ata, donde se promovía la participación de la comunidad en la planificación y aplicación de su atención en salud, naciendo el concepto de Atención Primaria de Salud, como estrategia tendiente para buscar “Salud para todos en el año 2000”, adoptándose la prevención y la promoción de la salud como acciones primordiales.
Se produjo la Declaración de Alma Ata, donde se promovía la participación de la comunidad en la planificación y aplicación de su atención en salud, naciendo el concepto de Atención Primaria de Salud, como estrategia tendiente para buscar “Salud para todos en el año 2000”, adoptándose la prevención y la promoción de la salud como acciones primordiales. -
 El año 1986 se produjo la Primera Conferencia Internacional sobre Promoción de la Salud en el Canadá, firmándose la Carta de Ottawa que definió la promoción de la salud como “el proceso que consiste en proporcionar a los pueblos los medios necesarios para mejorar su salud y ejercer un mayor control sobre la misma”.
El año 1986 se produjo la Primera Conferencia Internacional sobre Promoción de la Salud en el Canadá, firmándose la Carta de Ottawa que definió la promoción de la salud como “el proceso que consiste en proporcionar a los pueblos los medios necesarios para mejorar su salud y ejercer un mayor control sobre la misma”.
A list shows items. A timeline shows sequence.
Use Timetoast to make dates, milestones, and turning points easier to understand in a clear visual format. Timetoast is a timeline maker for work, school, research, and stories.